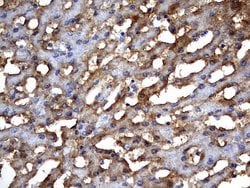
Invitrogen MSRB3 Monoclonal Antibody (OTI2A2) 100 &mu;L; Unconjugated:Antibodies,

missing translation for 'onlineSavingsMsg'
Learn More
Learn More
Invitrogen™ MSRB3 Monoclonal Antibody (OTI2A2)
Mouse Monoclonal Antibody
Brand: Invitrogen™ MA526601
This item is not returnable.
View return policy
Description
MSRB3 Monoclonal Antibody for Western Blot, IHC (P)
The protein encoded by this gene catalyzes the reduction of methionine sulfoxide to methionine. This enzyme acts as a monomer and requires zinc as a cofactor. Several transcript variants encoding two different isoforms have been found for this gene. One of the isoforms localizes to mitochondria while the other localizes to endoplasmic reticula.
Specifications
| MSRB3 | |
| Monoclonal | |
| 1 mg/mL | |
| PBS with 1% BSA, 50% glycerol and 0.02% sodium azide; pH 7.3 | |
| Q8IXL7 | |
| MSRB3 | |
| Human recombinant protein fragment corresponding to amino acids 33-192 of MSRB3 produced in E.coli. | |
| 100 μL | |
| Primary | |
| Human | |
| Antibody | |
| IgG1 |
| Immunohistochemistry (Paraffin), Western Blot | |
| OTI2A2 | |
| Unconjugated | |
| MSRB3 | |
| D430026P16Rik; DFNB74; I-8-23; methionine sulfoxide reductase B3; methionine-R-sulfoxide reductase B3; Methionine-R-sulfoxide reductase B3, mitochondrial; MsrB2; MsrB3; UNQ1965/PRO4487 | |
| Mouse | |
| Affinity Chromatography | |
| RUO | |
| 253827 | |
| -20°C, Avoid Freeze/Thaw Cycles | |
| Liquid |
Product Content Correction
Your input is important to us. Please complete this form to provide feedback related to the content on this product.
Product Title
Spot an opportunity for improvement?Share a Content Correction